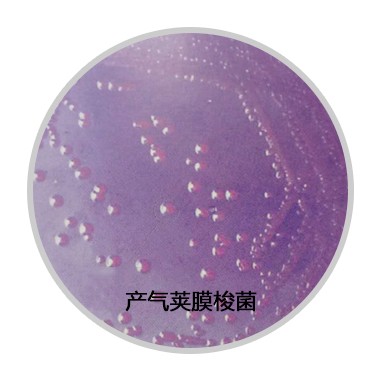

人畜共患病原菌——产气荚膜梭菌
人畜共患病原菌——产气荚膜梭菌
产气荚膜梭菌是一类革兰氏阳性(G+)产芽胞的厌氧性梭菌,广泛分布于污水、土壤、食物、人畜粪便及肠道中,是人畜共患病原菌。已经研究发现该菌能产生15种外毒素,其中最重要的致死性毒素有α、β、ε、ι 四种,按分泌毒素的类型可将该菌分为 A、B、C、D、E 五种。产气荚膜梭菌是引发组织毒害感染(如人类气性坏疽)和肠道疾病(如人类 D 型产气荚膜梭菌食物中毒和家畜肠毒血症)的重要因素。因此,有效的分离和鉴定产气荚膜梭菌对人类健康有着重要意义。
有报道指出,大肠菌群作为水质微生物学指标是不可靠的,而产气荚膜梭菌可作为一个水污染的指示菌。欧洲已将其作为水质卫生标准的补充条款,WHO已在水质检测中将其作为水质污染的微生物。产气荚膜梭菌数量与水污染程度有一定的相关关系。我国《食品安全国家标准 饮用天然矿泉水检验方法》GB8538—2016规定,天然矿泉水产品和水源水需检测产气荚膜梭菌。
目前,检测产气荚膜梭菌多采用培养基法和PCR法。HiMedia公司(国际知名微生物培养基生产商)生产的M-CP平板——梭菌显色培养基M1354(膜过滤法),根据Armon和Payment的配方而成。培养基中的胰蛋白䏡、酵母粉提供氮源营养,蔗糖提供碳源营养。溴甲酚紫为pH指示剂。吲哚β-D-葡萄糖苷为β-D-葡糖苷酶或纤维二糖酶的显色底物,二磷酸酚酞用于检测酸性磷酸化酶。添加的D-环丝氨酸和多粘菌素B(FD153)抑制伴随的其他菌群。厌氧环境也提供了进一步的选择性。当黄色(纤维二糖酶阴性)菌落在暴露于氨烟30秒后变为玫瑰红时,即可认为是产气荚膜梭菌。颜色鉴别有时是困难的,因此,可挑取典型菌落(黄变粉色)和非典型菌落(绿色或没变色)进行验证。验证试验可通过硫还原、革兰氏阳性、芽孢杆状、无动力性、硝还原、明胶液化、乳糖发酵和其他生化试验证实。实践证明,采用快速膜过滤技术和显色培养基(M-CP培养基),简单、易行、可靠,HiMedia公司生产的M-CP培养基在国际上得到广泛应用,如 Raed S. Al-Wasify等人,用显色介质检测水中某些病原菌的敏感性和特异性(Raed S. Al-Wasify, Al-Sayed A. Al-Sayed and Mohamed M. Kamel. Sensitivity and Specificity of Chromogenic Media for Detection of Some Pathogens in Water[J]. International Journal of Environment and Sustainability, 2013, 2(1): 1-9.)
-
- 全球最毒的树木,见血封喉堪称死亡之树
-
2025-10-09 05:33:59
-
- 普吉岛旅行防坑攻略
-
2025-10-09 05:31:44
-
- 美舰今早再穿台湾海峡,国防部回应
-
2025-10-09 05:29:29
-
- 聚“四心”共建“六清”美丽宜居乡村老道寺镇
-
2025-10-09 05:27:14
-
- 曾被三军仪仗队、海军陆战队选中的她,如今成了“神枪手”!
-
2025-10-08 09:21:07
-
- 沃尔沃架构,四驱+8AT,高保值,领克09能火不是没道理
-
2025-10-08 09:18:53
-
- 因红楼梦结缘,“贾琏”娶大三岁化妆师:我要老婆,不要花瓶
-
2025-10-08 09:16:38
-
- 上市公司近6000万元银行存款“不翼而飞”,后续来了......
-
2025-10-08 09:14:23
-
- 帕提亚:神圣古罗马也不过如此
-
2025-10-08 09:12:08
-
- 强行推销,当顾客面“内讧”,岳云鹏把《中餐厅》的脸都丢干净了
-
2025-10-08 09:09:53
-
- 柳州:歌神张学友来啦!看演唱会最全攻略都在这里了~
-
2025-10-08 09:07:38
-
- 魔方小白入门指南:七步公式口诀轻松还原魔方
-
2025-10-08 09:05:23
-
- 甘肃张掖十大景点有哪些?自驾游玩如何安排行程路线?
-
2025-10-08 09:03:08
-
- 东北最牛黑老大乔四,霸占24名女星,曾剁指立威,枪毙前淡定抽烟
-
2025-10-08 09:00:53
-
- 封神世界纯武艺出众的十个武将,实力都在黄飞虎之上
-
2025-10-08 08:58:38
-
- 你想不到清朝王朝,拥有火器重甲的八旗兵有多强
-
2025-10-08 08:56:23
-
- 「Hwa叔说广州」桥梁篇:海珠桥的岁月倾情(一)
-
2025-10-08 08:54:08
-
- 演员曹征:娶宋茶茶为妻,幸福结婚16年儿女双全
-
2025-10-08 08:51:53
-
- 孟浩然《望洞庭湖赠张丞相》赏析
-
2025-10-08 08:49:39
-
- 毛呢大衣不兴了,今年流行羊绒大衣,搭配这几条裤子超好看
-
2025-10-08 08:47:24



中国十大黑恶县城(中国十大黑恶县城有哪些)
【石井四郎的女儿还在吗】石井四郎女儿石井春海怎么死的?
元世祖忽必烈,一个在中国历史上留下了深刻印象的人物
世界上最贵的香烟,好彩香烟(60万一盒)
中国最严格的监狱(中国最严监狱排名)
中国最穷的十大城市,排名第一的是贵阳
中国十大超穷省会城市排行榜 贵阳第一
十大抗日小说排行榜 让你热血澎湃的经典之作
中国最狠十大监狱(女子监狱怎么解决需要)
中国“素质最差”三个省排行,国内“素质最差”省有哪些